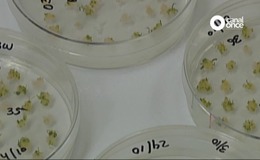

Factor Ciencia
Programa de divulgación científica, ágil y dinámico, que aborda interesantes temas de ciencia y tecnología de actualidad. Incluye reflexiones sobre el rumbo científico y tecnológico, su huella dentro de la sociedad, su aplicación cotidiana y se acerca a los protagonistas de la investigación en México y el mundo.